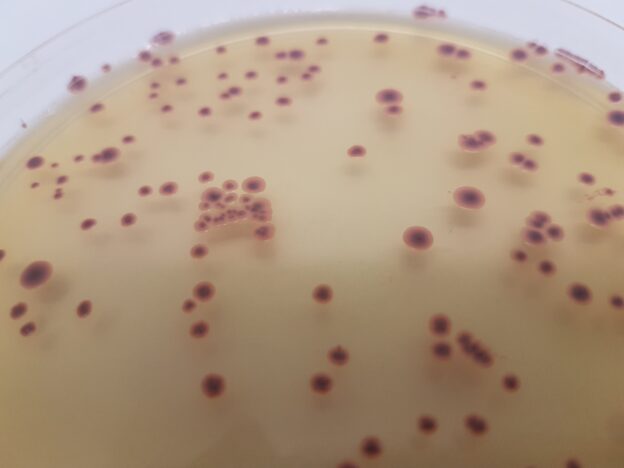

HRS Rapid sporothermodurans Agar
HRS Rapid sporothermodurans Agar permite detectar las esporas ultratermorresistentes de los alimentos UHT, antes de que salgan al mercado
https://www.microkit.es/fichas/HRS-RAPID-Cromogenic-sporothermodurans-Agar.pdf
INTRODUCCIÓN
La presencia de esporas altamente resistentes al calor de Bacillus sporothermodurans en leche pasterizada por el método Ultra Hight Temperature (UHT) se ha convertido en un problema importante en la industria láctea.
Su presencia se considera indeseable, ya que obstaculizan los requisitos de esterilidad comercial.
En un estudio (APPLIED AND ENVIRONMENTAL MICROBIOLOGY, Mar. 2005, p. 1480–1494), se han evaluado, mediante el uso de un selectivo tratamiento térmico de 30 minutos a 100°C, la presencia, fuentes, y naturaleza de las esporas potencialmente muy resistentes al calor en la leche cruda.
Se detectaron altos números de estas esporas en la tela del filtro del equipo de ordeño y en muestras de cultivos y forrajes verdes.
Se aislaron aproximadamente 700 cepas después del calentamiento selectivo. La colección de cepas mostró una notable diversidad, con representantes de siete géneros que forman esporas aerobias.
Las más frecuentes esporas aisladas de leche UHT han sido Bacillus sporothermodurans (aerobio facultativamente anaerobio), Brevibacillus borstelensis, Paenibacillus lactis, Bacillus sphaericus, Bacillus licheniformis, y Brevibacillus brevis.
El 23% de las 603 cepas formadoras de esporas pertenecen a 18 nuevas especies.
MÁS DATOS
La reducción de esta carga de esporas por buenas medidas higiénicas durante el ordeño probablemente podría reducir aún más el nivel de contaminación de la leche cruda.
Y de esta manera reducir al mínimo el recuento aeróbico de formadores de esporas de bacterias que podrían conducir al deterioro de la leche y los productos lácteos.
Las HRS (Heat Resistant Spores) o más coloquialmente “termorresistentes”, aparecen en muestras de leche UHT, sobre todo si el método de tratamiento térmico es “indirecto” (intercambiador de calor).
Los métodos “directos” con inyección de vapor sobrecalentado son más eficaces, pero estas esporas también aparecen de vez en cuando.
No son un problema para la salud (son microorganismos de riesgo biológico 1: sin riesgo para la salud) y aparentemente no alteran la leche, de modo que nos hemos acostumbrado a beber leche contaminada por estos microorganismos.
El problema no es para el consumidor, sino para la imagen de la industria.
MEDIO DE CULTIVO RÁPIDO
MICROKIT ha desarrollado un nuevo medio de cultivo cromogénico, HRS RAPID Cromogenic Agar derivado del HRS Cromogenic Agar original…
…con un nuevo factor “doping” adicional, que permite, de forma muy rápida (en sólo 36h en vez de las 72 h propias del Agar HRS), la visión de estas esporas germinadas, en forma de colonias, que suelen ser grandes, con forma de volcán y rojas, gracias a un cromógeno termoestable.
Este medio no es selectivo para B. sporothermodurans, de modo que también crecen en el mismo Bacillus licheniformis, Bacillus sphaericus (otras esporas termorresistentes o HRS) y los demás esporulados, así como otros alterativos de la leche UHT:
Por eso debe emplearse en leche UHT o en leche cruda o pasteurizada a la que sometamos previamente a un calentamiento UHT o similar que elimine los acompañantes no esporulados.
Solicite los precios actualizados en microkit@microkit.es
Si tiene dudas técnicas contacte con consultastecnicas@microkit.es
Haga sus pedidos en pedidos@microkit.es